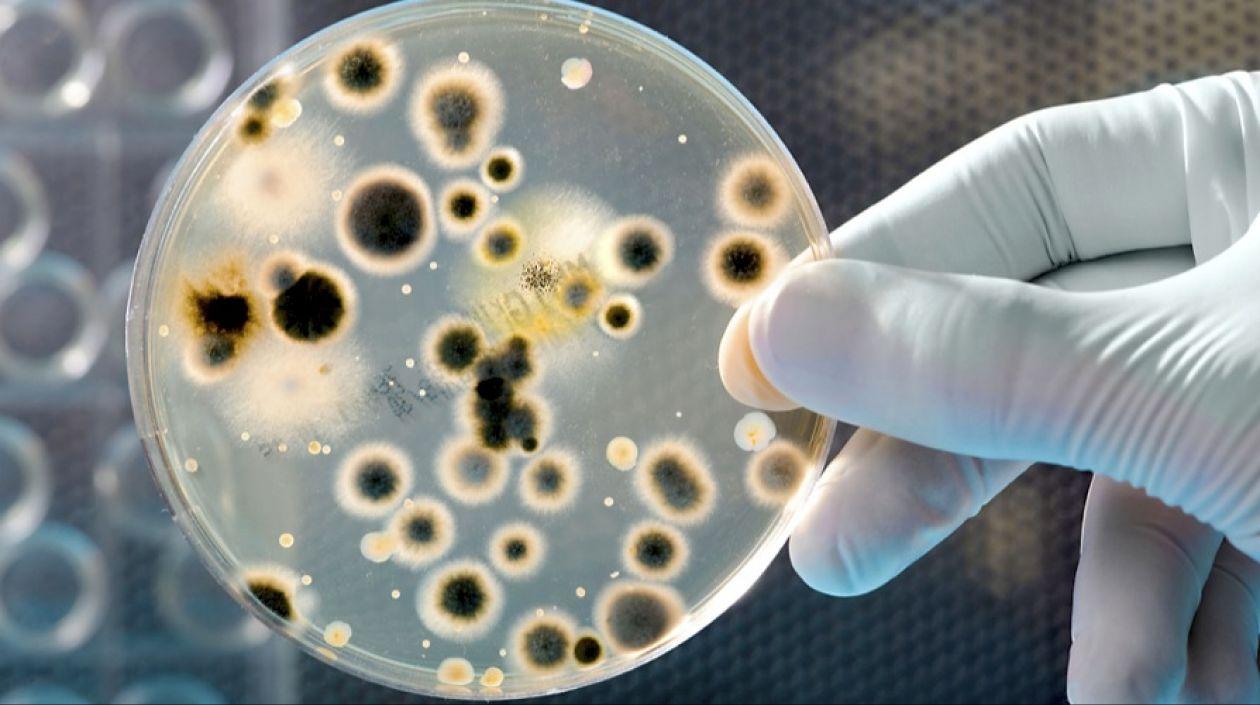
Las bacterias han adquirido capacidades para vencer a los antibióticos.

Identifican las cuatro superbacterias que más afectan a los latinoamericanos
Han adquirido capacidades para vencer a los antibióticos.
Investigadores de la Universidad del Bosque de Colombia lograron identificar, tras más de quince años de trabajo, las cuatro bacterias "superresistentes" a los antibióticos que más afectan a los latinoamericanos, en especial en hospitales.
Según el trabajo de los expertos, gérmenes como la "Escherichia coli", la "Klebsiella pneumoniae", la "Pseudomonas aeruginosa" y el "Staphylococcus aureus" han adquirido capacidades para vencer a los antibióticos y su número aumenta en los nosocomios de Latinoamérica.
"Estas son las cuatro 'superbacterias' con una gran capacidad de volverse resistentes y además causar múltiples infecciones en los pacientes hospitalizados", explicó a Efe la investigadora sénior de la casa de estudios y máster en microbiología Virginia Villegas.
En el caso de la peligrosa "Escherichia coli", la experta señaló que es una bacteria causante de infecciones urinarias e intraabdominales, mientras que la "Klebsiella pneumoniae", que se ha vuelto "superresistente ya que posee un material genético muy complicado", denominado carbapenemasas (kpc), produce neumonías y bacteriemias.
En tanto, el "Staphylococcus aureus" produce cierres en piel además de colonizar y generar daños en catéteres y prótesis, y la "Pseudomonas aeruginosa" causa neumonías violentas e infecciones severas que los pacientes contraen en el área de cuidados incentivos, ya que vive en las humedades y aguas.
Villegas añadió que los primeros tres microorganismos pueden vivir en el tracto gastrointestinal de los pacientes y desde allí infectarlos cuando estén hospitalizados, gracias a la baja de defensas o a la "situación de estrés que enfrentan", pasando a la sangre o al pulmón o a la orina.
En tanto, la "Pseudomonas aeruginosa" está en la piel de las personas y de allí ingresa al cuerpo a través catéteres.
Sobre este tema, cifras facilitadas por la experta afirman que un 30 % de las infecciones en hospitales son producidas por bacterias que el mismo paciente porta en su interior, mientras que otro 30 % provienen de malos hábitos de higiene en los centros hospitalarios, que carecen de políticas fuertes de lavado de manos o aseo general.
"Toda esta resistencia se ha diseminado en el mundo. Hay una tendencia universal, pero preocupa en Latinoamérica", alertó la investigadora del Grupo de Resistencia Bacteriana y de la Unidad de Genómica de la Universidad del Bosque, que trabaja en contacto con otros centros en la región y en países como España o Francia.
Por zonas geográficas, la investigación ha arrojado que en Colombia la mas peligrosa es la "K. pneumoniae", por ser resistente a casi todos los antibióticos disponibles en ese país, a la vez que hace presencia en Ecuador, Brasil y Argentina.
En Perú y Chile, predomina la "E.coli", que cuenta con una potente enzima para contrarrestar antibióticos conocida como BLEE.
Son precisamente esas enzimas, llamadas por lo general betalactamasas y producidas por las bacterias como mecanismo de defensa ante medios hostiles, las que les permiten a los microorganismos vencer la batalla contra los antibióticos.
Según Villegas, esto forma parte de "la evolución natural de las bacterias", ya que como "se replican espontáneamente, en ese ADN que ellas tienen ocurren mutaciones".
A eso hay que sumarle que los gérmenes están expuestos al medioambiente, en donde, "por ejemplo, hay sustancias tóxicas" a las que tienen que resistirse.
"Un ejemplo es la presencia de hongos que producen penicilina, conocida porque puede dañar a la bacteria. Ellas evolutivamente producen en su ADN enzimas que son capaces de protegerla", añadió.
La indagación científica también reconoce que el "lento y trabajoso" proceso de identificación de un antibiótico, así como su alto costo de desarrollo, está favoreciendo a los microorganismos.
Como recomendación a los Gobiernos, el equipo de expertos ha pedido que se creen mecanismos de contención nacional para este tipo de bacterias y fomentar políticas de higiene hospitalaria y de aislamiento de pacientes afectados.
"Aquí estamos trabajando, y en general en toda Latinoamérica como islas. Los hospitales tienen que hacer lo mejor que pueden, pero hay centros que no reciben este tipo de pacientes porque no los quieren tener y esa no es la idea", concluyó.
Este grupo de investigación al que pertenece Villegas ofrece servicios de asesoría a una decena de hospitales en toda América Latina y emite aletas cuando se identifica la presencia de microorganismos altamente peligrosos.
También ha sido reconocido por ser el primero en identificar una bacteria capaz de dañar todos los antibióticos "Cefalosporinas".
Los datos revelados por el grupo de investigación coinciden con la Semana Mundial de Concienciación sobre el Uso de los Antibióticos de 2017, que se celebra del 13 al 19 de noviembre y que tiene por lema "pida asesoramiento a un profesional sanitario cualificado antes de tomar antibióticos".
EFE




